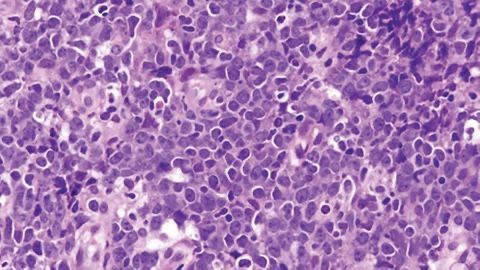
DLBCL

The CAR T-cell therapy axicabtagene ciloleucel demonstrated long-term disease control with rapid responses and robust CAR T-cell expansion among patients with refractory large B-cell lymphoma.

Your AI-Trained Oncology Knowledge Connection!



The CAR T-cell therapy axicabtagene ciloleucel demonstrated long-term disease control with rapid responses and robust CAR T-cell expansion among patients with refractory large B-cell lymphoma.

The CAR T-cell therapy elicited a 92% ORR, with high rates of durable responses in patients with indolent non-Hodgkin lymphoma.

A novel CD20xCD3 bispecific antibody, odronextamab, continues to show intriguing antitumor activity and an acceptable safety profile in patients with relapsed/refractory B-cell non-Hodgkin lymphoma, including those who have previously received chimeric antigen receptor T-cell therapy.

Regardless of age, Selinexor induced a clinical benefit in patients with relapsed/refractory diffuse large B-cell lymphoma.

A study presented at ASTRO suggested that response-based consolidation involved-field radiation therapy appears to be a safe and effective standard of care for a cohort of pediatric patients with high-risk classical Hodgkin lymphoma.

The FDA has accepted and granted priority review to the biologics license application (BLA) for loncastuximab tesirine (Lonca) for the treatment of relapsed or refractory diffuse large B-cell lymphoma.

The priority review of the biologics license application for lisocabtagene maraleucel (liso-cel) for the treatment of adults with relapsed or refractory large B-cell lymphoma after at least 2 prior therapies will not be completed by the prescription drug user fee act date.

In June 2020, the FDA approved tazemetostat (Tazverik) for 2 distinct follicular lymphoma indications based on overall response rate and duration of response observed in phase 2 clinical trial cohorts of patients with follicular lymphoma with EZH2 mutations and wild-type EZH2.

Cycle 3 of the FLASH study reported that patients taking SGX301 to treat cutaneous t-cell lymphoma saw improved responses and maintained a positive safety profile.

The study established 4 cycles of rituximab, cyclophosphamide, doxorubicin, vincristine, and prednisone (R-CHOP) alone as the new standard approach for the majority of patients with limited-stage diffuse large B-cell lymphoma.

This phase 1 study found that vorinostat (Zolinza) in combination with either sirolimus (Rapamune) or everolimus (Afinitor) demonstrated clinical efficacy in patients with relapsed and/or refractory Hodgkin lymphoma and warrants further investigation.

The FDA approved an expanded label for pembrolizumab (Keytruda) as monotherapy for the treatment of adult patients with relapsed or refractory classical Hodgkin lymphoma.

The study is evaluating copanlisib (Aliqopa) in combination with rituximab (Rituxan) in patients with indolent non-Hodgkin’s lymphoma who have relapsed after 1 or more prior lines of rituximab-containing therapy.

Researchers identified molecular and cellular characteristics of anti-CD19 CAR T-cell infusion products associated with how patients with large B-cell lymphoma respond to treatment and experience adverse events.

Results from the phase 1/2 ALEXANDER study found the investigational CAR T-cell product AUTO3 in combination with pembrolizumab to have a tolerable safety profile and elicit durable complete responses in patients with relapsed/refractory diffuse large B-cell lymphoma.

The submission is based on results from the phase 2 LOTIS 2 clinical trial, which is evaluating the efficacy and safety of loncastuximab tesirine in patients with relapsed or refractory DLBCL following at least 2 lines of prior systemic therapy.

The supplemental new drug application seeks approval for crizotinib (Xalkori) to treat pediatric patients with relapsed or refractory systemic anaplastic large cell lymphoma that is ALK positive.

The updated guidelines now include tafasitamab-cxix in combination with lenalidomide with a category 2A designation as an option for the treatment of previously-treated adult patients with relapsed or refractory DLBCL not otherwise specified.

The FDA recently announced updates to the adverse event-related data pertaining to breast implant illness and breast implant-associated anaplastic large cell lymphoma.

Nirav Niranjan Shah, MD, discussed the analysis of autologous transplantation use in patients with relapsed, chemosensitive DLBCL and how it may become a comparator for other clinical trials.

Novartis announced that the study met its primary end point of complete response rate in patients with relapsed or refractory follicular lymphoma.

The FDA has approved tafasitamab-cxix in combination with lenalidomide for the treatment of adult patients with relapsed or refractory diffuse large B-cell lymphoma.

Interim results from the study suggested that axicabtagene ciloleucel (axi-cel) demonstrated significant and durable clinical benefit in patients with relapsed or refractory indolent non-Hodgkin lymphoma.

The agent is now the first and only approved CAR T-cell therapy to treat adult patients with relapsed or refractory mantle cell lymphoma.
Researchers were able to establish possible mechanisms that may contribute to racial differences in incidence, patterns of presentation, and survival in patients with DLBCL with African ancestry.